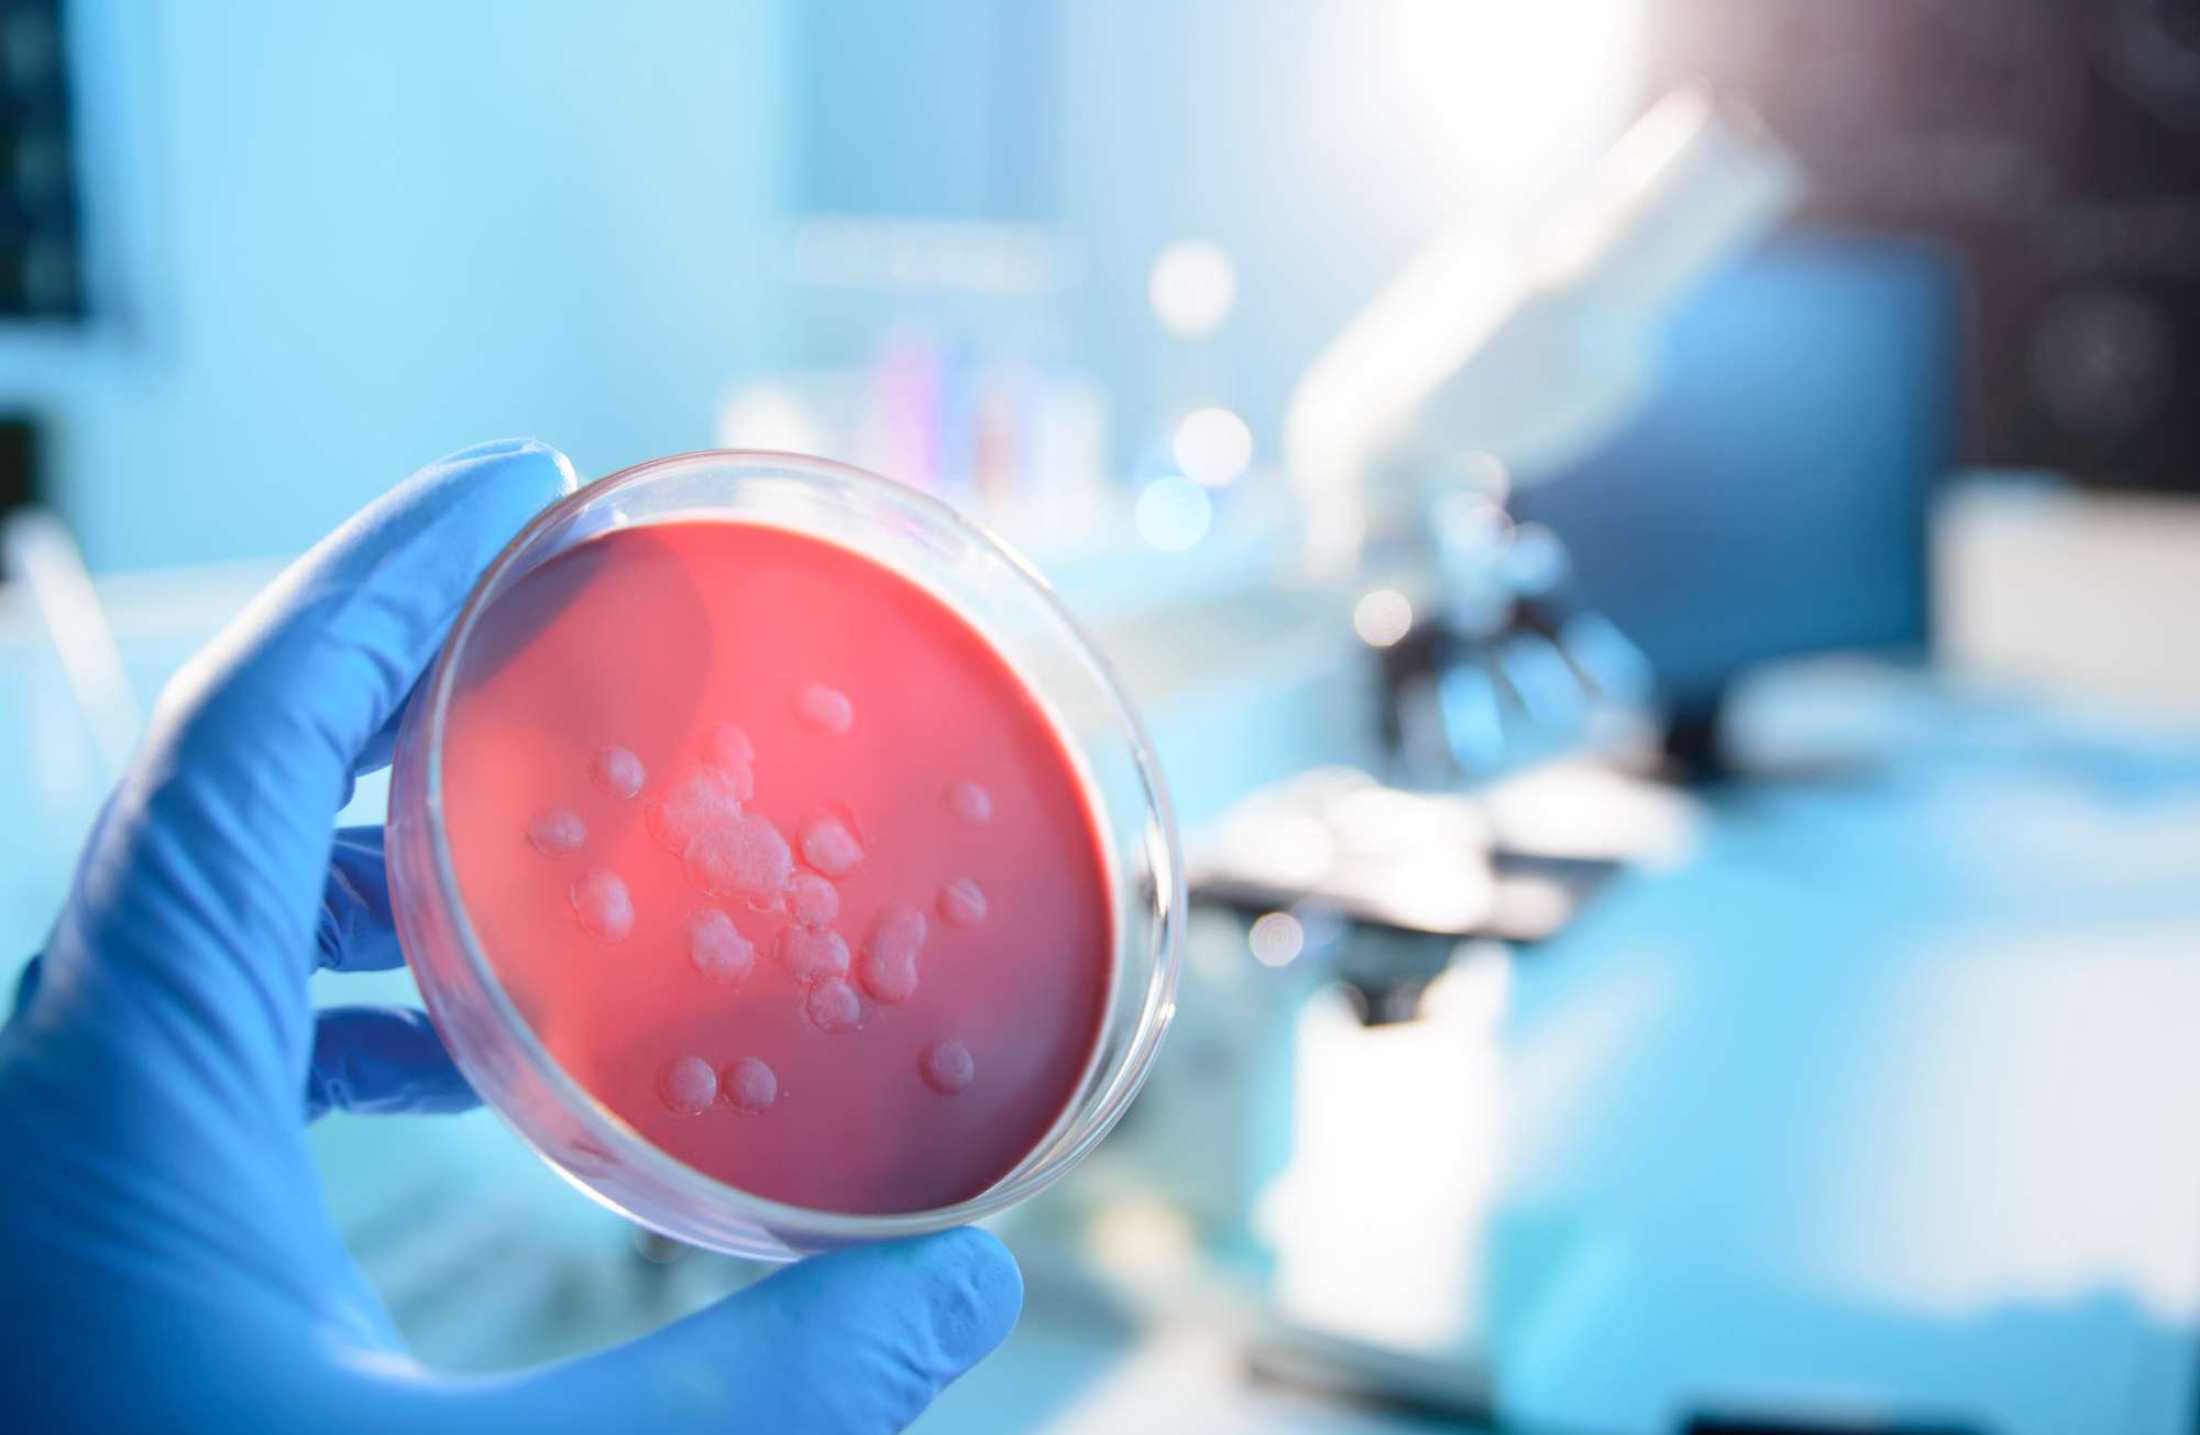

Ebola e vírus Marburg: entenda as semelhanças entre eles
Após a mais recente pandemia sanitária causada pelo coronavírus, causador da Covid-19, a população mundial ficou ainda mais atenta às formas de contágio, medidas de isolamento e taxas de letalidade de vírus que circulam pelo mundo.
Entretanto, mesmo antes dessa pandemia, um grande número de cientistas e médicos infectologistas já unia forças para estudar e diminuir as possibilidades de contágio de outros vírus ainda mais letais. Dois exemplos desses vírus são o Ebola e o Marburg, que apresentam semelhanças e são da mesma família viral, mas causam quadros diferentes.
No post de hoje, você vai entender mais sobre cada um desses vírus e as doenças que eles causam, além de relembrar últimos surtos e quais são as principais diferenças entre o vírus Ebola e o vírus Marburg. Boa leitura!
O que é vírus Ebola?
O vírus Ebola foi reconhecido pela primeira vez no fim da década de 1970, devido a epidemias em regiões da África subsaariana. O vírus é considerado uma zoonose, isso é, um vírus que transita entre animais e seres humanos. Embora a origem do vírus não seja conhecida, sabe-se que os morcegos são seus principais hospedeiros.
Antes conhecida como febre hemorrágica Ebola, é possível destacar que seus principais sintomas envolvem uma febre alta e manifestações hemorrágicas como sangramentos internos e erupções na epiderme.
Além desses sintomas, o Ebola, que já tem cinco subtipos conhecidos, pode ser identificado pelos seguintes sintomas:
- dores de cabeça;
- náuseas e vômitos;
- dores de cabeça;
- dores abdominais e no corpo;
- desarranjo intestinal e diarreia.
Segundo o portal do Ministério da Saúde brasileiro, um dos maiores fatores de preocupação do vírus é a taxa de mortalidade, que pode chegar a impressionantes 90%.


O que é vírus Marburg?
Assim como o vírus Ebola, o vírus Marburg faz parte da família de vírus Filoviridae, conhecida por ser uma zoonose com alta taxa de mortalidade. No caso do vírus Marburg, ela pode chegar a até 88%.
Com uma origem muito semelhante, o vírus Marburg foi descoberto em 1967, na Alemanha. Entretanto, há evidências de que as pessoas infectadas no país retornavam ou tiveram contato com pessoas que retornavam de países africanos. A ocorrência desse vírus no continente africano é explicada pela presença do morcego Rousettus aegyptiacus, popularmente conhecido como morcego-da-fruta, principal hospedeiro do vírus.
Por se tratar de um vírus da família Filoviridae, os sintomas são clinicamente muito semelhantes ao quadro causado pelo vírus Ebola. Também é possível destacar sintomas como:
- mal-estar generalizado;
- febre alta;
- manifestações hemorrágicas;
- dores musculares;
- náuseas e vômitos.
Grande parte dos infectologistas, uma das áreas da Medicina que ganharam força com a pandemia, frisa que, como a doença está longe de ser assintomática e tem uma taxa de mortalidade severa, a taxa de contágio é menor e o risco de uma pandemia é extremamente baixo.
Quais foram os últimos surtos de cada doença?
Como você viu, o vírus Ebola já é conhecido pela humanidade há muitas décadas. De maneira geral, pequenas epidemias eram resolvidas em um curto espaço de tempo sem causar um alarme significativo.
Esse não foi o caso do surto de Ebola que se iniciou em 2013 e só teve um fim em 2016, afetando principalmente os países da África central, mas cidadãos europeus e asiáticos indiretamente.
Condições socioeconômicas e culturais facilitaram a rápida transmissão do vírus Ebola no continente, causando mais de 11 mil mortes em países como Libéria e Serra Leoa, e deslocando um grande número de profissionais, como a médica Margaret Chan, uma das médicas que fizeram história na Medicina.
Já no caso do vírus Marburg, nunca houve uma emergência sanitária com as mesmas proporções. Em março de 2023, existiu uma preocupação no território da Guiné Equatorial, depois que 10 pessoas foram diagnosticadas com Marburg e existe a possibilidade de que o vírus tenha sido transmitido para mais pessoas.
Mesmo que não seja possível colocar esses quadros como doenças comuns no Brasil e o país não espere que esses vírus se tornem uma preocupação mais real, já existem protocolos de segurança sanitária preparados para qualquer eventualidade.
Principais diferenças entre Marburg e Ebola
Agora que você já está bem mais familiarizado com o vírus Ebola e o vírus Marburg e quais foram os principais episódios de surtos relacionados às doenças causadas por estes agentes patógenos, é hora de descobrir que existem algumas diferenças importantes entre eles.
Como você viu, os dois vírus fazem parte da mesma família de vírus Filoviridae. Por essa razão, existem pontos em comum e que podem dificultar o diagnóstico. A seguir, entenda alguns fatores que diferenciam os vírus.
Maior virulência do vírus Ebola
A principal diferença entre esses dois vírus é a taxa de mortalidade de cada um deles. Embora os dois representantes da família Filoviridae tenham taxas de letalidade muitos altas, a do vírus Ebola é superior e causa mais preocupação.
Essa letalidade é muito alta por conta de um dos principais sintomas do vírus Ebola, que é encontrado com menos força no Marburg: as manifestações hemorrágicas. Além de combater outros sintomas, o corpo também é afetado por sangramentos generalizados que podem causar a morte muito rapidamente.
Inexistência de vacinas para o vírus Marburg
Embora ainda careça de muitos investimentos e aprovações por agências em todo o mundo, já existe uma vacina que confere proteção contra uma das cinco variantes do vírus Ebola. Segundo publicação da Organização Mundial de Saúde, a vacina chamada rVSV-ZEBOV é promissora e só é usada em alguns casos, como:
- pessoas enfrentando surtos de Ebola;
- profissionais da saúde trabalhando no combate a epidemias;
- trabalhadores de laboratórios expostos ao vírus.
Ainda que o vírus Marburg só possua uma cepa original conhecida, o que facilitaria a produção de uma vacina eficiente, ainda não existem previsões de descoberta e produção da substância.
Formas de tratamento
A maioria dos tratamentos para pessoas infectadas com o vírus Ebola e Marburg envolvem apenas cuidados paliativos e tratamento de sintomas específicos, como remédios para baixar as febres altas e analgésicos para as dores musculares.
No trato médico, não é incomum o uso de oxigenoterapia, isso é, fornecimento de oxigênio para o sistema respiratório com o auxílio de aparelhos para o caso de pacientes com dificuldades respiratórias.
Para ambos os quadros, outra recomendação básica é a ingestão de muito líquido e alimentação saudável. já que a água e nutrientes são fundamentais para fluidificar os sistemas do organismo e manter as barreiras imunológicas funcionando no combate à infecção.
Recomendações como essas são ainda mais necessárias para o caso de pessoas que se enquadram em fatores de risco das doenças, como:
- visitas à locais com transmissão comprovada do vírus Ebola ou Marburg;
- profissionais da saúde que tiveram contato com pessoas infectadas;
- pessoas com contato direto com animais que são considerados hospedeiros.
Gostou de saber mais sobre estes dois vírus?
Nesse post, você entendeu mais sobre dois vírus que causaram um grande impacto global por seus surtos e altas taxas de letalidade: o vírus Marburg e o vírus Ebola, descobertos desde os anos 1960.
Além disso, você também viu que, embora eles pertençam a mesma família viral, existem algumas diferenças nas taxas de mortalidade e também na forma de tratamento, já que existe um projeto avançado de pesquisa para vacina de Ebola. Além disso, você também viu alguns cuidados gerais e fatores de risco das doenças.
Gostou do conteúdo! Então não perca mais nenhum post sobre saúde, bem-estar e outros assuntos importantes para a carreira médica. Siga a Afya nas redes sociais. Você consegue nos encontrar no LinkedIn, Instagram, Facebook e no YouTube.

